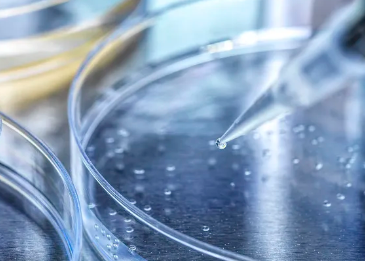
image.png

多大年紀(jì)不能干細(xì)胞移植手術(shù),年齡會(huì)影響手術(shù)效果嗎
2024-12-05 14:10:27 來(lái)源: 小編 咨詢醫(yī)生
干細(xì)胞移植手術(shù)作為一種新性的醫(yī)療技術(shù),已經(jīng)在治療多種疾病中取得了顯著成效。然而,關(guān)于多大年紀(jì)不能進(jìn)行干細(xì)胞移植手術(shù),以及年齡是否會(huì)影響手術(shù)效果,一直是業(yè)內(nèi)關(guān)注的焦點(diǎn)。本文將圍繞這一話題,為您詳細(xì)解答。
一、多大年紀(jì)不能干細(xì)胞移植手術(shù)?
干細(xì)胞移植手術(shù)的適用年齡范圍較廣,一般來(lái)說(shuō),年齡在18-60歲之間的患者更適合進(jìn)行干細(xì)胞移植。這是因?yàn)樵谶@個(gè)年齡段,患者的身體機(jī)能相對(duì)較好,對(duì)手術(shù)的承受能力較強(qiáng)。然而,這并不意味著超過(guò)60歲的患者就不能進(jìn)行干細(xì)胞移植手術(shù)。實(shí)際上,在一些特殊情況下,如某些血液病、免疫系統(tǒng)疾病等,超過(guò)60歲的患者也可以在醫(yī)生評(píng)估后接受干細(xì)胞移植手術(shù)。
二、年齡會(huì)影響手術(shù)效果嗎?
1.年齡對(duì)干細(xì)胞移植手術(shù)的影響
年齡是影響干細(xì)胞移植手術(shù)效果的一個(gè)重要因素。隨著年齡的增長(zhǎng),人體內(nèi)的干細(xì)胞數(shù)量和質(zhì)量會(huì)逐漸下降,這可能導(dǎo)致干細(xì)胞移植手術(shù)的效果受到影響。此外,年齡較大的患者術(shù)后恢復(fù)較慢,并發(fā)癥風(fēng)險(xiǎn)較高。
2.年齡并非唯一因素
雖然年齡對(duì)干細(xì)胞移植手術(shù)效果有影響,但并非唯一因素。以下因素同樣值得關(guān)注:
(1)疾病類型:不同疾病的干細(xì)胞移植手術(shù)效果有所不同。例如,某些血液病、免疫系統(tǒng)疾病的患者在干細(xì)胞移植后效果較好,而某些神經(jīng)系統(tǒng)疾病的患者效果較差。
(2)患者體質(zhì):患者體質(zhì)良好、免疫力較強(qiáng)的患者,在干細(xì)胞移植手術(shù)后的恢復(fù)和治療效果方面更有優(yōu)勢(shì)。
(3)手術(shù)技術(shù):隨著醫(yī)療技術(shù)的不斷發(fā)展,干細(xì)胞移植手術(shù)成功率逐漸提高,手術(shù)技術(shù)對(duì)手術(shù)效果的影響日益減小。
三、總結(jié)
總之,多大年紀(jì)不能干細(xì)胞移植手術(shù)并沒有一個(gè)明確的界限,年齡只是影響手術(shù)效果的一個(gè)因素。在實(shí)際操作中,醫(yī)生會(huì)根據(jù)患者的具體情況,如疾病類型、患者體質(zhì)、手術(shù)技術(shù)等,綜合評(píng)估患者是否適合進(jìn)行干細(xì)胞移植手術(shù)。因此,患者在咨詢醫(yī)生時(shí),應(yīng)詳細(xì)告知自己的年齡、疾病情況等信息,以便醫(yī)生做出更為準(zhǔn)確的判斷。在干細(xì)胞移植手術(shù)的保駕護(hù)航下,許多患者重獲新生,改善了生活質(zhì)量。
-
上一頁(yè): 干細(xì)胞四大功效作用是什么,如何正確選擇干細(xì)胞治療
- 2024-11-04臉部干細(xì)胞注射有哪些作用?
- 2024-10-12哪些機(jī)構(gòu)能儲(chǔ)存干細(xì)胞?選擇時(shí)需要注意什么?
- 2024-10-22死精癥干細(xì)胞技術(shù)有效嗎?成功率是多少?
- 2024-10-29韓國(guó)干細(xì)胞治療的研究進(jìn)展,哪方面治療效果好?
- 2024-10-26干細(xì)胞霧化效果的神奇作用你了解嗎?
- 2024-10-05干細(xì)胞再生療法進(jìn)展如何?目前有哪些成功案例?
- 2024-10-09臉部松弛打干細(xì)胞效果真的好嗎,如何選擇靠譜的干細(xì)胞機(jī)構(gòu)
- 2024-08-27注入干細(xì)胞多久有效果,治療周期與效果評(píng)估
- 2024-09-11干細(xì)胞抗衰老最新成果,這些方面取得重大突破
- 2024-07-22干細(xì)胞治療眼病,干細(xì)胞療法在眼科疾病中的應(yīng)用
- 2024-08-08干細(xì)胞存儲(chǔ)費(fèi)用,干細(xì)胞存儲(chǔ)有必要嗎
- 2024-08-20什么是造血干細(xì)胞移植,造血干細(xì)胞移植的基本流程
- 2024-10-11干細(xì)胞儲(chǔ)存的費(fèi)用是多少?如何確保儲(chǔ)存的安全可靠?
- 2024-10-08鹽城干細(xì)胞價(jià)格是多少?與效果有何關(guān)聯(lián)?
- 2024-09-20上海打干細(xì)胞收費(fèi)標(biāo)準(zhǔn)詳解
- 2024-08-03免疫療法干細(xì)胞,免疫干細(xì)胞是什么
- 2024-08-22干細(xì)胞移植的副作用,干細(xì)胞移植利弊
- 2024-08-14干細(xì)胞療法治療疾病靠譜嗎
